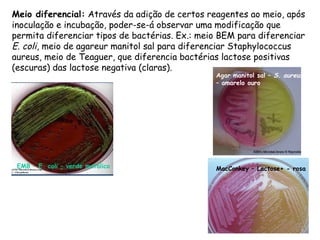
Meio diferencial: Através da adição de certos reagentes ao meio, após
inoculação e incubação, poder-se-á observar uma modificação que
permita diferenciar tipos de bactérias. Ex.: meio BEM para diferenciar
E. coli, meio de agareur manitol sal para diferenciar Staphylococcus
aureus, meio de Teaguer, que diferencia bactérias lactose positivas
(escuras) das lactose negativa (claras).
MacConkey – Lactose+ - rosaEMB – E. coli – verde metálico
Agar manitol sal – S. aureus
– amarelo ouro

Este documento descreve normas de segurança, técnicas e conceitos básicos utilizados em laboratório de microbiologia, incluindo cultura pura, esterilização e assepsia. A prática 1 ensina identificação de equipamentos, transferência de culturas e detecção de microrganismos ambientais. A prática 2 aborda métodos físicos e químicos de controle de crescimento, como calor e agentes antissépticos.